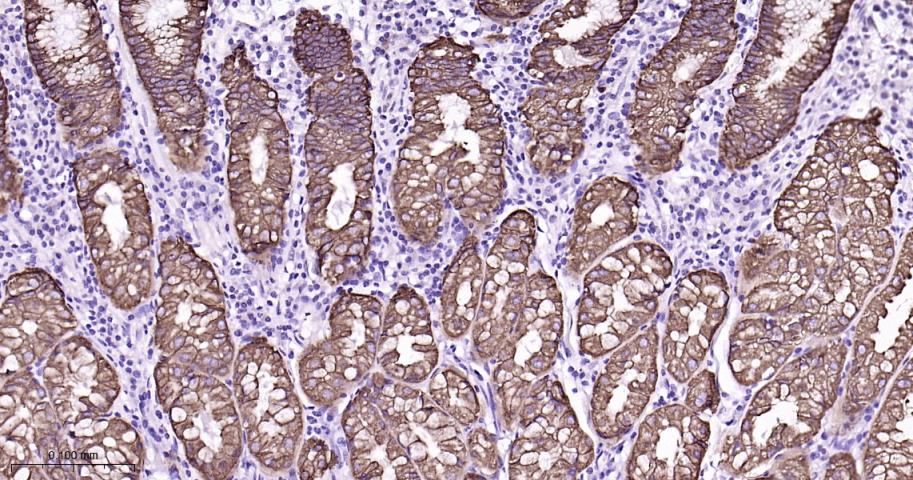
细胞角蛋白8重组兔单抗

Cytokeratin 8 Recombinant Rabbit mAb (一抗) - WB,IHC-P,IHC-F,IF,ICC/IF | Bioss

概述
细胞角蛋白是一类与结构相关的蛋白家族,其在上皮细胞中形成细胞骨架中间丝。CK8存在于某些正常腺上皮及其肿瘤,包括许多导管上皮和腺上皮,如结肠、胃、小肠、气管的上皮和尿路上皮。CK8主要用于腺癌和导管癌的诊断,该抗体特异识别第23位丝氨酸磷酸化的CK8。
This gene is a member of the type II keratin family clustered on the long arm of chromosome 12. Type I and type II keratins heteropolymerize to form intermediate-sized filaments in the cytoplasm of epithelial cells. The product of this gene typically dimerizes with keratin 18 to form an intermediate filament in simple single-layered epithelial cells. This protein plays a role in maintaining cellular structural integrity and also functions in signal transduction and cellular differentiation. Mutations in this gene cause cryptogenic cirrhosis. Alternatively spliced transcript variants have been found for this gene. [provided by RefSeq, Jan 2012].
Cytokeratin 8 is a member of the type II keratin family clustered on the long arm of chromosome 12. Type I and type II keratins heteropolymerize to form intermediate-sized filaments in the cytoplasm of epithelial cells. Cutokeratin 8 typically dimerizes with keratin 18 to form an intermediate filament in simple single-layered epithelial cells. This protein plays a role in maintaining cellular structural integrity and also functions in signal transduction and cellular differentiation. Mutations in this gene cause cryptogenic cirrhosis.

产品应用
| 应用 | 已检合格种属 | 预测种属 | 推荐稀释比例 |
|---|---|---|---|
| WB | Human | Mouse, Rat | 1:1000-5000 |
| IHC-P | Human, Mouse, Rat | 1:200-800 | |
| IHC-F | Human, Mouse, Rat | 1:200-800 | |
| IF | Human, Mouse | Rat | 1:200-800 |
| ICC/IF | Human | Mouse, Rat | 1:100-500 |
交叉反应
交叉反应: Human, Mouse, Rat
相关产品
暂无相关产品
靶标
O-glycosylated. O-GlcNAcylation at multiple sites increases solubility, and decreases stability by inducing proteasomal degradation.
O-glycosylated (O-GlcNAcylated), in a cell cycle-dependent manner.